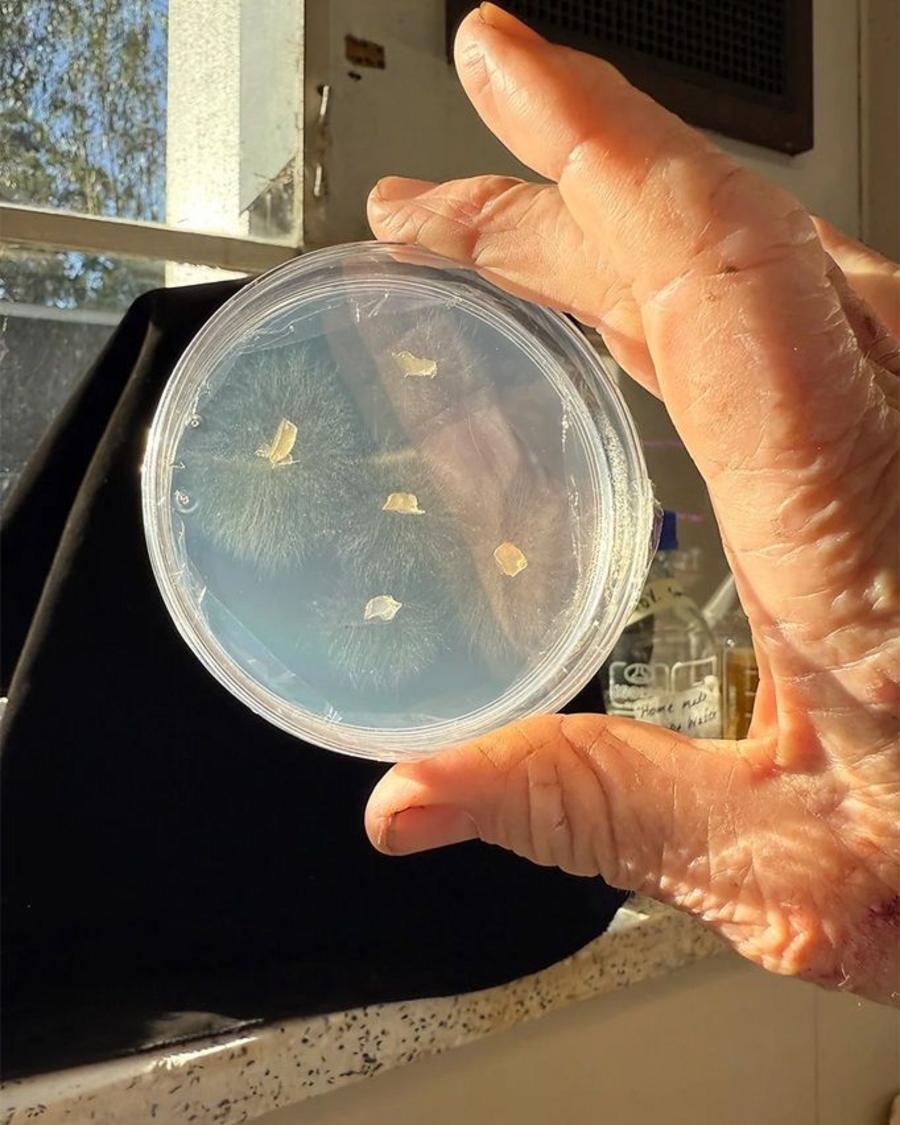

Самая загадочная и редкая орхидея мира выращивает под землей в Австралии. Ученые теперь прилагают все усилия, чтобы спасти эту ботаническую красоту от полного исчезновения.
Австралийский профессор ботаники Кингсли Диксон, когда он был ребенком, очень любил книгу о диких орхидеях с его родной земли.
Особенно захвачено одной иллюстрацией — рисункой орхидеи Rhizanthella Gardneri, которая широко называется западной австралийской подземной орхидеей.
Я посмотрел на это и не мог поверить: орхидея, но она растет под землей! Был моей мечтой, — говорит он.
Впервые ему удалось увидеть ее жизнь только через 24 года во время исследовательской экспедиции в маленький город Бабакин в Западной Австралии.
«Мы перестали пить чай… Я пошел в лес и случайно копал землю — и увидели цветные приступки орхиды. Это был очень эмоциональный момент ». Самые редкие орхидеи в мире. Это буквально уравновешивает границу исчезновения из -за потери природной среды.
Осталось очень мало растений в дикой природе — согласно Диксону Кингсли, их число меняется каждый год, и в последние годы это произошло только три живых орхидеи, или ни одна из них не меняется, ситуация, все более осложняется. Этот вид превратился из уникальной находки до почти полного исчезновения: Диксон узнает с грустью. И теперь у него есть новая мечта — чтобы спасти этот удивительный подземный цветок от последнего исчезновения.
Особая связь: орхидея, гриб и кустарник
. Жизнь — это настоящая ботаническая аномалия: она прорастает, развивается, расцветает и образует семена, не появляясь на поверхности. Bush of Melaleuca uncinata. То, что у него нет питательных веществ для роста, — объясняет Калево. — Долгосрочный без такого грибного орхидеи просто не выживет
Тепло и пожар
Калево исследовал влияние изменения климата на орхидею в Западной Австралии.
В рамках великого международного проекта, который объединяет Королевский ботанический сад в Лондоне и Австралийский университет Кертина, он моделировал, как повышение температуры до 5 ° C в течение столетия повлияет на 26 орхидеев в течение столетия.
Результаты исследования еще не были опубликованы, но это уже видно: большинство орхидей могут адаптироваться к экстремальной жаре. Например, орхидеи пауков скрывают свои клубни глубже в землю, где они прохладнее.

Но тепло — это только одна из проблем. Калево предупреждает, что более частые лесные пожары могут нанести гораздо больший вред.
Исследование 2025 года показало, что из 17 видов орхидей, кроме Rhizanthella, две трети страдали от пожаров, и только одна треть выиграла от них.
Вместо этого синяя солнечная орхидея (Thelymitra macrophyllla) была почти полностью разрушена на территориях, покрытых огнем.

В 2022 году огонь уничтожил кусты Меллейки и изменил грибные сообщества в почве, из -за орхидеи не могла расти.
Однако через два года грибы и кустарники начали восстанавливаться. Это дает надежду, что подземная орхидея также вернется, если пожары не произойдут слишком часто.
Основной угрозой для редких орхидей является потеря естественной среды обитания. Растения не могут переехать, если нет нигде.
Сохранение вида
. Для спасения ризантеллы от вымирания ученые не только защищают свои участки естественного роста, но и способствуют знанию уникальной орхидеи.
В мае 2025 года они представили специальную экспозицию, посвященную этому загадочному заводу на лондонской выставке.
Это было уже в 1990-х годах, но затем коллекция была убита из-за ошибки-орхидеи просто высохли из-за неправильного полива.
Тогда в дикой природе все еще было около 180 растений. Сегодня — гораздо меньше, и шансы на маленькие.
Диксон теперь восстанавливает «подземную экосистему» в горшках. Грибы и кусты уже растут. Следующий шаг — сеять семена орхидеи и надеяться, что он прорастает.
Для Диксона эта кропотливая работа — не просто наука, а вопрос жизни, основанный на великой любви к этому уникальному растению.















